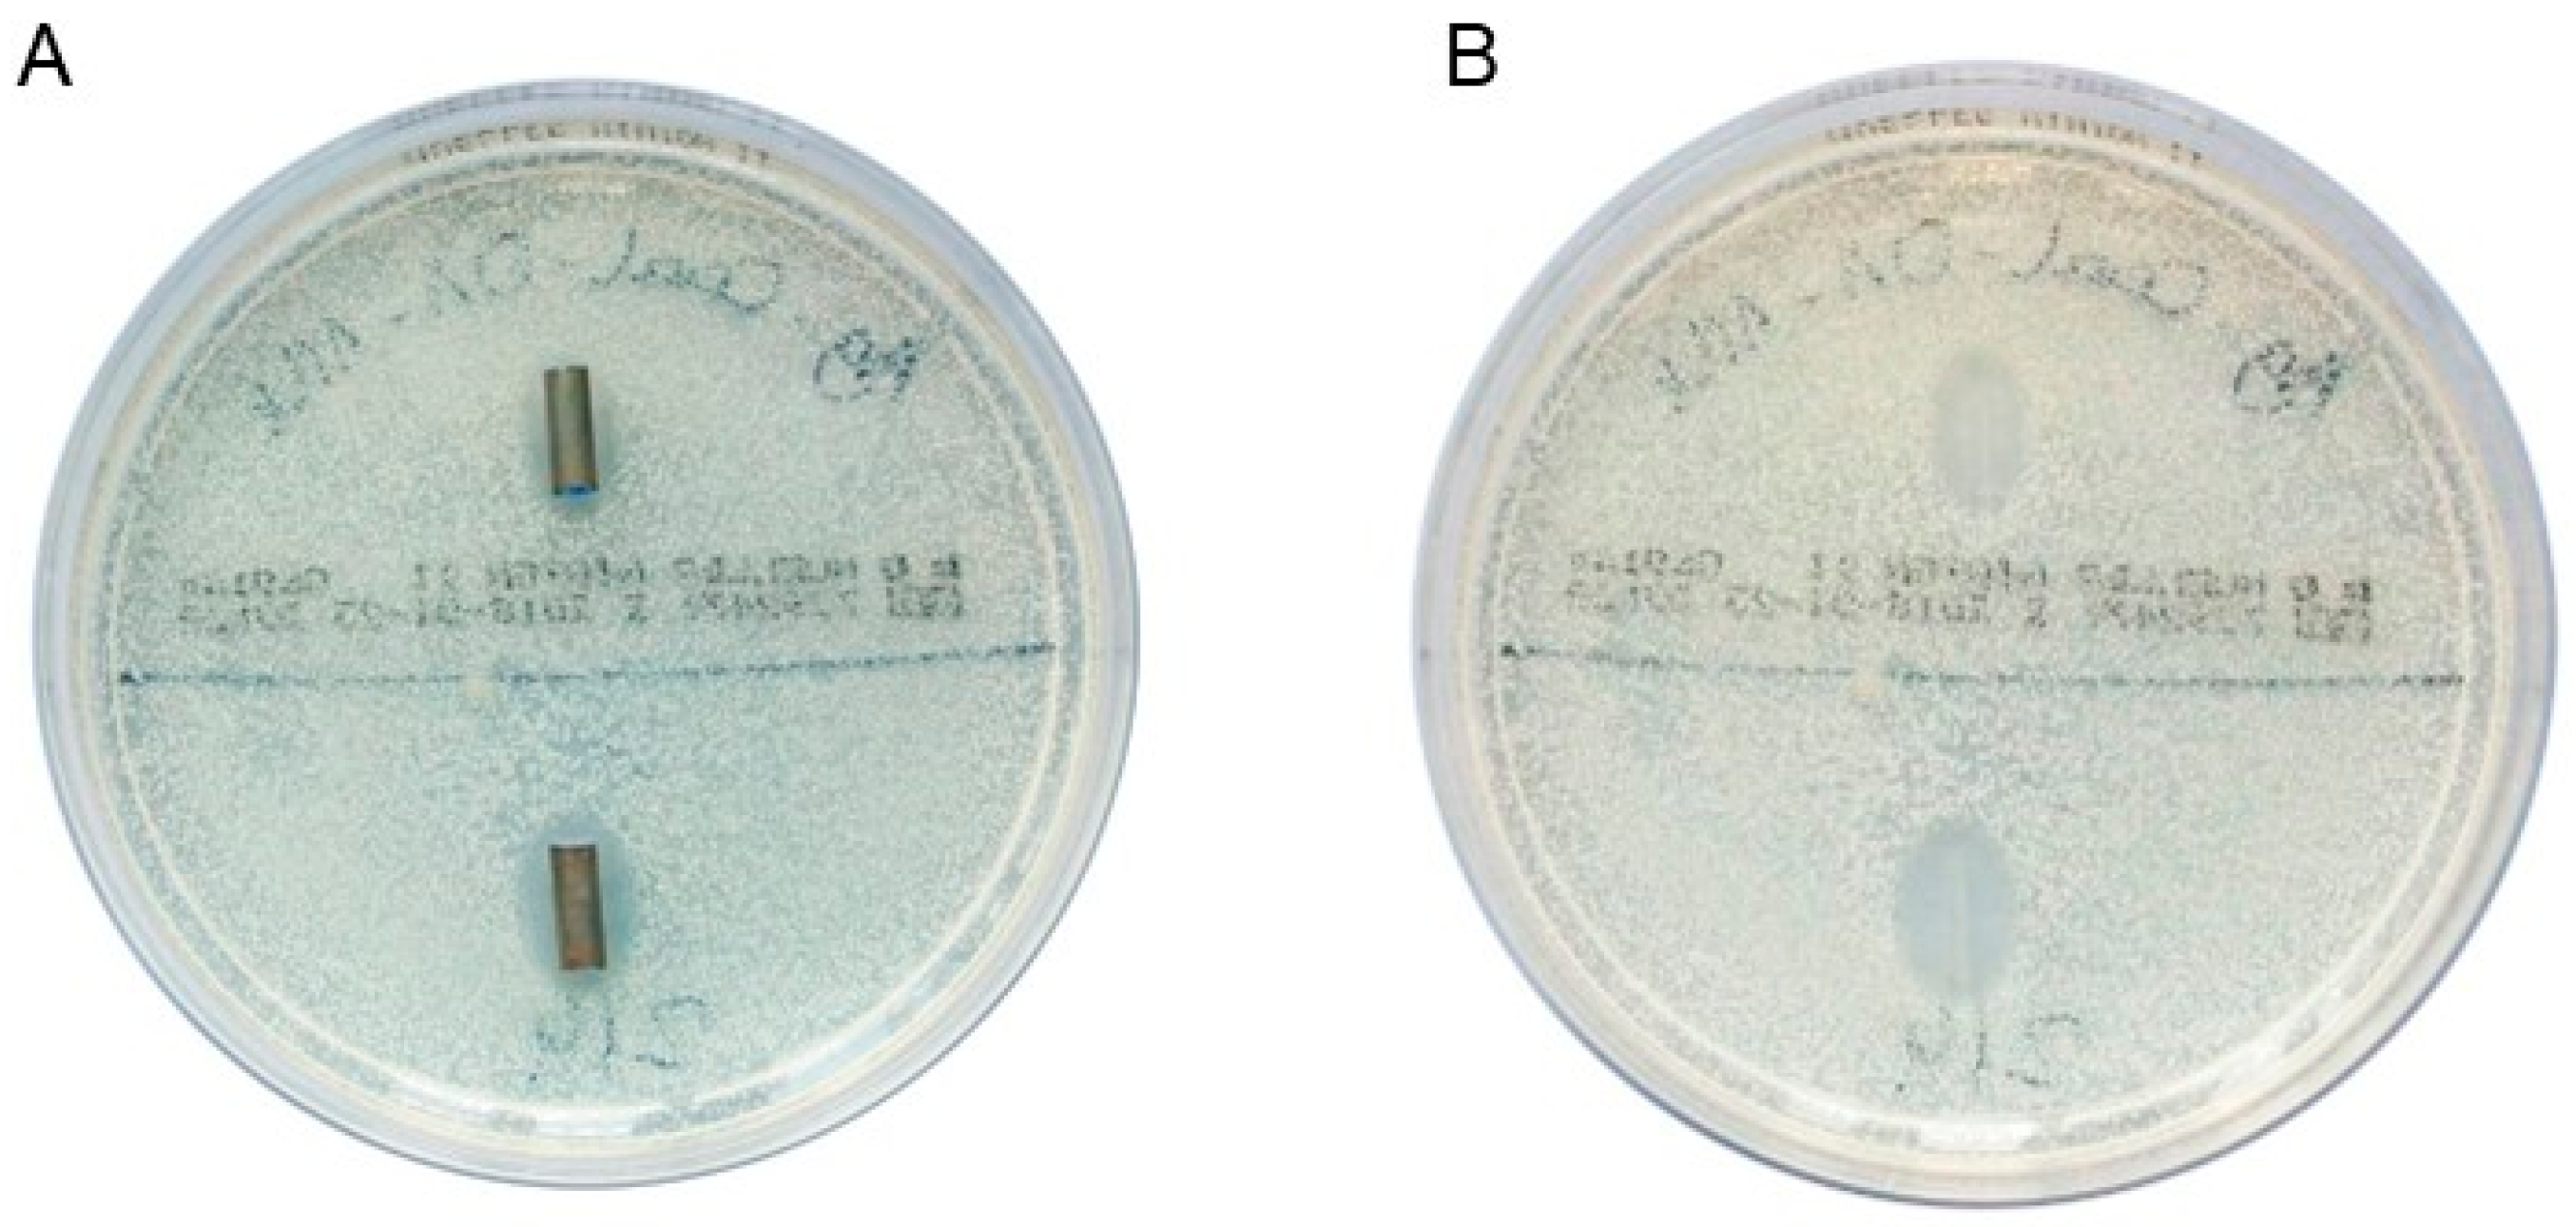
Biomedicines 13 01950 g001

1. Introduction
In cases of biliary obstruction, bile flow can be restored through endoscopic stent insertion via endoscopic retrograde cholangiography (ERC). Both plastic and metal stents are available, with selection depending on the etiology, length, and location of the obstruction [
1]. A common complication of plastic biliary stents is occlusion [
2], which occurs earlier than with metal stents due to their smaller diameters. Stent technology limits the diameter of lumens that can be applied, particularly for plastic stents, as they must pass through the endoscope. The median patency of plastic stents is 70–126 days, and the risk of stent occlusion increases significantly after 3 months [
2,
3,
4]. This common complication usually requires a stent replacement every 2–4 months [
5]. Hence, plastic stents are changed approximately every 3 months to avoid stent occlusion and associated complications, such as cholangitis [
6,
7]. The primary cause of stent occlusion is sludge accumulation, driven by microbial colonization and subsequent biofilm formation on the stent surface [
8,
9]. The composition of microbial colonization changes over time. Initially, aerobic gram-positive bacteria and
Candida species (spp.) are present. After more than 60 days, aerobic Gram-negative and Gram-positive bacteria, along with anaerobes, become dominant. The most frequently identified microorganisms on biliary stents are
Enterococcus spp. and
Enterobacteriaceae, followed by
Candida spp. [
2,
3]. Several strategies have been explored to prolong stent patency. In addition to antimicrobial coatings [
10], anti-adhesive coatings have emerged as promising alternatives. These coatings modify the stent surface by altering its physicochemical properties to prevent microbial adhesion [
11].
A promising strategy to address this challenge involves the application of diamond-like carbon (DLC) coatings doped with antimicrobial elements, such as silver (Ag) or copper (Cu). DLC coatings have also been applied to metallic cardiac stents, where they demonstrated favorable hemocompatibility and reduced clot formation, supporting their clinical relevance in other biomedical fields [
12]. Such coatings have demonstrated beneficial properties, including surface smoothness, chemical inertness, biocompatibility, and antimicrobial activity [
13,
14,
15]. Harrasser et al. [
16,
17] investigated Ag- and Cu-DLC coatings on orthopedic-grade high-density polyethylene (HDPE) and reported significant bactericidal effects, particularly for Ag. Similarly, Gorzelanny et al. [
18] showed that comparable Ag concentrations can be both antimicrobial and cytocompatible, supporting a potential therapeutic window for Ag-DLC coatings on soft biomaterials. However, their study used ion implantation techniques at elevated process temperatures—conditions that are not compatible with the thermally sensitive materials used in polymeric biliary stents. In addition, their work was performed on orthopedic implant substrates, under conditions that do not reflect the complex composition of human bile or its associated microbiota. Birkett et al. [
19] and Vishwakarma et al. [
20] recently reviewed multifunctional DLC coatings and emphasized their potential for various medical applications. However, most of the published studies focus on orthopedic or cardiovascular environments. While polymeric stents with DLC coatings have been studied in urological settings, their efficacy in bile-exposed environments remains unexplored [
21]. Furthermore, no previous study has examined Ag-DLC coatings in the context of thermally labile polymeric biliary stents under biliary-specific conditions—such as bile exposure and mixed-species biofilm formation involving Gram-positive, Gram-negative bacteria, and fungal organisms (e.g.,
Escherichia coli (E. coli),
Enterococcus faecalis (E. faecalis), and
Candida albicans (C. albicans)).
To address this gap, our study adapts established DLC coating processes (PlasmaImpax and pulsed laser deposition (PLD)) to medical-grade polyethylene (PE) stents, using low-temperature settings and other process parameters compatible with the substrate. We evaluated non-doped DLC and Ag-DLC coatings in a simulated bile model that mimics physiological conditions relevant to biliary drainage. Importantly, our approach builds upon the deposition parameters and antimicrobial insights of Harrasser et al. but extends their application to a different material and organ system. Accordingly, we formulated the following research questions: (i) Can DLC and Ag-DLC coatings be successfully applied to thermally sensitive PE stents using the employed DLC processes without damaging the substrate? (ii) Do these coatings reduce microbial adhesion and bile sludge accumulation under in vitro conditions mimicking the biliary tract environment?
We hypothesize that Ag-DLC coatings exert a dual anti-biofouling effect—reducing both microbial colonization and sludge accumulation—which may ultimately prolong stent patency and reduce the need for repeated interventions in the future.
2. Materials and Methods
2.1. Microorganisms
E. faecalis (ATCC
®29212™),
E. coli (ATCC
®25922™), and
C. albicans (ATCC
® 90028™) were selected as test species due to their prevalence in bile duct stents within the first 15 days post-insertion [
3].
Microorganisms were pre-cultured on Columbia Blood Agar (CBA) (Becton Dickinson GmbH, Heidelberg, Germany) or Mueller–Hinton Agar (MHA) (Sigma-Aldrich, Merck KGaA, Darmstadt, Germany), and in Mueller–Hinton Broth II (MHB) (Becton Dickinson GmbH, Heidelberg, Germany) or Dulbecco’s Modified Eagle’s Medium (Sigma-Aldrich, Merck KGaA, Darmstadt, Germany) to prepare standardized bacterial suspensions for testing.
2.2. Biliary Plastic Stents
Uncoated PE biliary straight stents (10 French, EndoStay®, Peter Pflugbeil GmbH, Zorneding, Germany) served as reference standards. Stents were cut into 10.0 mm sections for testing, while 5.0 mm sections were prepared for scanning electron microscopy (SEM) in the bile incubation model.
2.3. Coating Solutions for Plastic Stents
DLC was investigated as a novel anti-adhesive coating for biliary plastic stents. DLC refers to a class of amorphous carbon thin-film materials with diamond-like properties [
22]. AxynTeC Dünnschichttechnik GmbH, Augsburg, Germany, applied three coatings, namely DLC-1 (a-C:H), DLC-2 (ta-C), and DLC-2-Ag (ta-C:Ag). DLC-1, previously approved for coating metallic surgical instruments, was adapted for plastic stents using the PlasmaImpax process, a plasma-enhanced chemical vapor deposition (PECVD) method. The PlasmaImpax process is a hybrid technique combining plasma-assisted chemical vapor deposition (CVD) and ion implantation. This allows for the deposition of hydrogenated amorphous carbon (a-C:H) coatings at low substrate temperatures (approximately 200–250 °C), suitable for polymer substrates. The resulting coatings feature a layer thickness of 2–3 µm, a low coefficient of friction, and high hardness due to an sp
3 bonding content of 30–50%, while maintaining elasticity [
23]. DLC-2 was applied via the PLD method. PLD is a physical vapor deposition method in which a pulsed laser beam ablates a solid carbon target. The resulting plasma plume deposits a hydrogen-free ta-C film on the substrate. This method allows precise control of the sp
2/sp
3 ratio and coating characteristics. In the case of DLC-2-Ag, the film was additionally doped with Ag ions during the PLD process [
24]. All stents—both plastic and DLC-coated—were sterilized in a drying oven at 80 °C prior to their use in the experimental series.
Table 1 gives an overview of the different coating solutions and processes.
2.4. Quantification of Microbial Test Organisms
Microbial suspensions and supernatants were quantified using a spectrophotometer (Biophotometer, Eppendorf GmbH, Hamburg, Germany) by measuring optical density at 600 nm (OD 600) to produce standardized inocula. To determine pathogen adherence, stents were eluted, and serial dilutions were plated on agar to quantify colony-forming units (CFU). After incubation on CBA plates, colonies were imaged and counted using ImageJ 1.52a, Open Access Freeware software, to calculate CFU/mL concentrations.
2.5. Agar Diffusion Assay
The agar diffusion assay (zone-of-inhibition assay) is a well-established microbiological method for assessing the antimicrobial efficacy of drug-releasing samples. In this study, it was used to evaluate DLC-2-Ag stent samples.
Liquid cultures of
E. faecalis,
E. coli, and
C. albicans were prepared, adjusted to OD 600 of 0.1, and then 400 µL of each culture was plated on MHA agar. Once the liquid was absorbed, the stent samples were placed on the agar using sterile tweezers and incubated at 37 °C for 24 h. The following day, the stents were transferred to fresh MHA plates and examined for microbial growth inhibition. The inhibition zone diameter was measured using calipers. For every microorganism, four stent samples were investigated (
n = 4).
Figure 1A shows the two DLC-2-Ag-coated stent samples after 1 day of incubation in a culture of
C. albicans. Figure 1B shows the inhibition zones after removing the stent samples.
2.6. Microbial Adhesion Assay (Using Monocultures in MHB for Stent Incubation)
A microbial adhesion assay was conducted to quantify viable microorganisms adhering to the stent surfaces. Stent samples were incubated in bacterial suspensions using monocultures in MHB, and adhered bacteria were detached via sonication. The number of CFU was determined by plating the bacterial suspension on CBA agar followed by 24 h incubation, to quantify adhered bacteria. Additionally, bacterial load in the supernatant was assessed for drug-releasing stents to evaluate the samples’ potential antimicrobial effects on the surrounding environment.
The adhesion of
E. faecalis was tested on DLC-1 and DLC-2 samples, while
E. coli adhesion was tested on DLC-2-Ag samples. Two test series were conducted for DLC-1 (
n = 8 for both series), one for DLC-2 (
n = 8), and three for DLC-2-Ag (
n = 7 for all three series regarding the supernatant;
n = 7 and
n = 8 for test series 2 and 3 regarding surface adhesion), all incubated in a bacterial suspension without human bile (
Supplementary Table S1).
The adhesion assay spanned 3 days per experimental round: Day 1: Preparation and incubation—stent samples were secured at the bottom of the wells in a microtiter plate (Falcon
® 24-well TC-treated plates (Corning Life Sciences, Tewksbury, MA, USA; distributed by VWR International GmbH, Darmstadt, Germany). Subsequently, stents were exposed to bacterial suspensions with adjusted initial densities and incubated at 37 °C for 24 h. Initial bacterial densities were as follows: DLC-1: 1 × 10
4/mL (test series 1) and 1 × 10
3/mL (test series 2); DLC-2: 1 × 10
4/mL; DLC-2-Ag: 3 × 10
5/mL (test series 1 and 2) and 3 × 10
4/mL (test series 3). Day 2: Supernatant and surface analysis—bacterial suspensions from the supernatant were collected, chemically neutralized, diluted 10-fold, and plated for CFU counting. Stents were washed, sonicated, and vortexed to detach adhered bacteria, which were then plated using the same method. Day 3: colony counting—CFU were counted from CBA plates to quantify bacteria in both the supernatant and stent surfaces. This modified protocol builds on methods established by Heidenau et al. [
25] and Obermeier et al. [
26].
2.7. Bile Incubation Model (Using Co-Culture of Main Pathogens in Human Bile for Stent Incubation)
Stent samples (DLC-1, DLC-2, and DLC-2-Ag) were incubated in human bile inoculated with defined concentrations of 1 × 103/mL of the test strain (E. faecalis, E. coli, and C. albicans) to simulate physiological conditions inside the bile duct. Human bile samples were collected during elective cholecystectomies at the TUM School of Medicine and Health, Department of Surgery, University Medical Center, Technical University of Munich, Germany. To ensure defined microbiological culture conditions, it was necessary to maintain sterility. Sterility was confirmed by incubating 100 µL of bile at 37 °C for 24 h on CBA plates. Only pooled human bile samples without colony formation were used in experiments. Additional microbiological analyses were conducted to investigate the non-sterile bile obtained from patients and to assess the pathogenic environment affecting stent materials in situ.
2.8. Collection and Characterization of Human Bile for in Vitro Testing
The aerobic bacterial spectra of non-sterile bile samples were analyzed using a matrix-assisted laser desorption/ionization time-of-flight (MALDI-TOF) mass spectrometer (TUM School of Medicine and Health, Institute for Medical Microbiology, Immunology and Hygiene, TUM University Hospital, Munich, Germany)
For sterile bile samples,
E. faecalis,
E. coli, and
C. albicans were added to achieve a total bacterial density of 3 × 10
3/mL. Stent samples were secured with paraffin inside a microtiter plate (Falcon
® 6-well clear flat bottom TC-treated cell culture plates (Corning Life Sciences, Tewksbury, MA, USA), obtained via VWR International GmbH, Darmstadt, Germany), with separate plates for each stent type. Wells were filled with 7.5 mL of inoculated bile, sealed, and incubated at 37 °C on a shaker (Polymax 1040, Heidolph Scientific Products, Schwabach, Germany) at 2 revolutions per minute to simulate bile flow for 5 or 14 days.
Figure 2 shows the arrangement of the multi-well plates in the bile incubation model.
Microbial adhesion to the stent surface and bacterial concentration in the surrounding bile were assessed using an adhesion assay. Stents were weighed pre- and post-incubation to quantify sludge accumulation following protocols by Dowidar et al. [
27] and Farnbacher et al. [
28]. Weighing was performed using a precision balance (ATL-224, Sartorius Acculab Atilon, Göttingen, Germany), and stents were stored in Stericlin
® bags. After incubation, stents were washed in phosphate-buffered saline, dried on mounted pipette tips to remove non-adherent sludge, and air-dried for 3 days to ensure a stable weight before final measurement.
High-resolution surface changes were analyzed using SEM. After incubation, stents were fixed with glutaraldehyde in phosphate-buffered saline, dehydrated using an ascending ethanol series, and dried with hexamethyldisilazane. Samples were examined using a ZEISS SIGMA VP Field Emission SEM (Carl Zeiss AG, Oberkochen, Germany) at the Institute of Water Chemistry, Technical University of Munich. Non-incubated native samples were also analyzed to compare the surface properties of PE- and DLC-coated stents.
The bile incubation model included three experimental rounds (
Table 2). In round one (14 days), all three analytical methods (adhesion assay, weight analysis, and SEM) were applied. Round two (14 days) included the adhesion assay and weight analysis; SEM was omitted as a significant portion of the adherent sludge detached during preparation. The datasets from rounds one and two were statistically standardized, and results were based on both test series (adhesion assay:
n = 12 for surface adhesion,
n = 3 for the supernatant; weight analysis:
n = 16). Round three (5 days) assessed the short-term anti-adhesive effect using an adhesion assay (
n = 8 for surface adhesion,
n = 2 for the supernatant).
2.9. Statistics
Statistical analyses were performed using Microsoft Excel, Version 16.92 (Microsoft Corporation, Redmond, WA, USA). The Kolmogorov–Smirnov test assessed normal distribution. Normally distributed datasets were analyzed using an independent-sample t-test, while non-normally distributed datasets were evaluated with the Mann–Whitney U test. All tests were two-sided, and statistical significance was set at p < 0.05.
2.10. Ethics
The use of human bile from patients undergoing elective cholecystectomy was approved by the Ethics Committee of the Technical University of Munich (approval number 391/18). This study adhered to the principles of the Declaration of Helsinki.
4. Discussion
Occlusion of biliary PE stents is a common complication following ERC due to sludge accumulation and biofilm formation from bacterial adhesion [
3]. DLC, a polymorphic group of carbon compounds, has anti-adhesive properties, making it suitable as a coating [
29]. Doping with Ag ions further enhances antimicrobial effectiveness [
30].
This study is the first to systematically investigate the anti-adhesive effects of DLC coatings with Ag doping on PE biliary stents. The stent material was incubated in human bile with a defined bacterial density, simulating the clinical situation in vitro, a novel approach.
E. faecalis and
E. coli were the most commonly detected pathogens in non-sterile human bile from patients who underwent elective cholecystectomy, consistent with previous studies on bile pathogens [
2,
3], supporting the choice of
E. faecalis,
E. coli, and
C. albicans for testing. Neither DLC-1- nor DLC-2-coated PE stents exhibited anti-adhesive effects against
E. coli or
E. faecalis. Kulikovsky et al. [
31] conducted an in vitro study with plastic biliary stents coated with DLC-Ag incubated with human bile. Agar diffusion tests showed inhibition zones around DLC-Ag-coated stents, unlike the reference samples. However, this study did not analyze stents coated exclusively with DLC (without Ag doping) and had methodological deficiencies.
Numerous plastic stents and catheters, especially in urology, have been developed to maintain urine flow [
32]. Two comparable studies examined the effects of DLC coatings on urethral stents and bladder catheters. Watari et al. [
33] coated the inner lumen of a silicon tube (2 mm diameter) using alternating-current (AC) high-voltage methane PECVD. They found reduced adherence of
Pseudomonas aeruginosa (
P. aeruginosa) and
E. coli compared with uncoated tubes and inhibition of
P. aeruginosa biofilm and microcolony formation. Laube et al. [
34] showed similar results in vivo with DLC-coated polyurethane ureteral stents. They also used the PECVD method, but the comparability of our study is limited due to the unreported coating quality and possible biofilm assessment by cystoscopy alone.
Differences between our results and those of Watari et al. may be due to variations in coating quality. Our SEM images revealed delamination and cracks in the DLC coating, particularly after fluid incubation, leading to increased microbial adhesion in these areas. The edges of the coating may serve as micro-scale niches where bacterial colonization is more likely than on smooth surfaces. This issue could stem from the cylindrical shape of the stents, which makes it difficult to apply DLC coatings uniformly. Excessive layer thickness could also contribute to delamination, though the exact thickness was not measured. However, standardized coatings from AxynTeC Dünnschichttechnik GmbH, the company responsible for the coatings, typically range from 1–6 µm [
35].
While DLC coatings for metallic substrates have been optimized, adapting these techniques to polymeric silicone remains challenging. DLC adhesion depends on such factors as substrate lattice spacing and coating temperature. Lower coating temperatures, pretreatments, and intermediate layers are essential to ensure strong adhesion to polymeric silicone [
36]. Future research should focus on refining the coating process to enhance adhesion and quality, potentially by adjusting parameters during production (e.g., variations in sp
2 and sp
3 bonding) or using intermediate layers as adhesion promoters. CVD and PECVD coatings have shown significant promise in enhancing mechanical durability and reducing microbial adhesion in preclinical and in vitro studies, but their clinical effectiveness—specifically in biliary drainage stents—remains experimental. To our knowledge, no large-scale clinical trials have definitively confirmed improved clinical outcomes solely due to CVD/PECVD-applied DLC coatings in the biliary setting. Nevertheless, CVD coatings have demonstrated benefits in related medical applications [
12,
37]. These findings support the rationale for applying similar technologies to polymeric biliary stents and the need for further in vivo and clinical research.
Another future research objective is to compare the established PECVD technique with the more advanced AC high-voltage methane plasma CVD method. Watari et al. reported a high-quality DLC coating with a smooth surface and structural integrity even after 2 months of urine exposure, achieved using AC high-voltage methane plasma CVD. This technique is specifically tailored for intraluminal coatings of small-diameter stents, as methane plasma remains confined within the tube, enabling uniform deposition [
38]. However, due to its complexity and limited availability, this method was not used in our study. A key limitation of our approach is that PE stents could only be coated externally due to their small diameter and the coating process itself. This is significant because bacterial biofilms tend to develop inside stents rather than on their outer surface. PECVD, while widely used for coating planar and metallic objects, poses challenges when applied to the curved, narrow lumen of bile duct stents due to restricted accessibility [
39]. Further studies should validate the use of AC high-voltage methane plasma CVD for intraluminal coatings, as it represents a promising advancement in addressing one of the primary limitations of current stent-coating methods.
DLC-2-Ag formed an inhibition zone in agar diffusion assays against
E. coli,
E. faecalis, and
C. albicans for 4 days. The antibacterial action of Ag involves binding to cellular membranes, enzymes, and nucleic acids, disrupting the respiratory chain, and impairing aerobic metabolism in microorganisms [
30]. Ag nanoparticles (AgNPs) can also adhere to bacterial cell walls, increasing membrane permeability and causing disintegration [
21]. Several in vitro studies have demonstrated Ag’s antimicrobial effects. Yang et al. [
21] showed that doping plastic biliary stents with Ag prolonged patency and provided broad antimicrobial efficacy against
E. coli,
Staphylococcus aureus,
Enterococcus, and
P. aeruginosa. Wen et al. [
40] found that polyurethane stents doped with AgNPs reduced bacterial adhesion when preclinically implanted in pigs with bacterial cholangitis. Similar findings were reported by Park et al. [
41], Lee et al. [
42], and Yamabe et al. [
43] in studies on Ag-doped metal and plastic biliary stents, reinforcing Ag’s antimicrobial ability. Metal stents inherently have longer patency than plastic stents due to their larger diameter, whereas plastic biliary stents are typically replaced every 3 months [
7]. Although Ag doping improved plastic stent patency in non-clinical studies, its duration remains debatable, given the small stent diameter and limited Ag release period [
30]. In this study, DLC-2-Ag-coated stents reduced bacterial adhesion in the bile incubation model for over 5 days but had no relevant effect after 14 days. In contrast, Yang et al. reported sustained antimicrobial efficacy of AgNPs doping for up to 48 weeks due to the slow release of Ag
+ in biliary stents. Ag’s antimicrobial effects appear proportional to its concentration and dependent on release dynamics [
16]. This release can be modulated by incorporating additional carrier elements or compounds, enhancing Ag’s mechanical stability [
44]. In addition to carbon, silicon polymers and titanium are suitable Ag carriers for inhibiting bacterial growth on surfaces [
17,
18,
42,
45]. In our study, a single predefined Ag concentration was used, based on previous data indicating sufficient antimicrobial activity without cytotoxicity. However, systematic variation of the Ag dopant concentration was not performed and will be the subject of future investigations. Dose-dependent efficacy and release profiles will be essential to optimize long-term stent patency under biliary conditions. In addition to silver, alternative antimicrobial ions, such as copper (Cu) and zinc (Zn), are also under investigation for surface modification of biomedical devices. Previous studies have shown that Cu-doped DLC coatings can reduce bacterial growth depending on the deposition method, although their performance in vivo may be limited by increased encrustation in fluid-exposed environments [
17,
46]. Zn has demonstrated strong in vitro antimicrobial activity and biocompatibility in implant settings [
47]. Alternative dopants may complement silver’s antimicrobial effects and should be systematically evaluated in future studies under biliary-specific conditions, considering ion release kinetics, biocompatibility, and biofilm inhibition potential. Therefore, the novel coated stents in this study require further optimization, with Ag release characterized and adapted for clinical bile duct applications to maintain patency for at least 3 months.
In summary, this is, to our knowledge, the first study to transfer DLC-Ag coating techniques to thermosensitive polymeric biliary stents and to evaluate their anti-adhesive performance under simulated bile conditions. Unlike previous works performed on HDPE or metallic substrates, our study mimics the physiological complexity of the biliary tract, including bile composition and relevant microbial species. These findings suggest a potential translational benefit for improving the patency and longevity of biliary drainage systems.
Our results demonstrate that both DLC and DLC-Ag coatings can be applied to thermosensitive PE stents using a low-temperature PECVD-based process without compromising the substrate’s integrity, thereby affirmatively addressing research question (i). Furthermore, quantitative adhesion tests and SEM analyses revealed that DLC-Ag coatings significantly reduced microbial attachment and bile sludge accumulation compared to uncoated controls. While variability remained high and some comparisons did not reach statistical significance, the observed trends support the hypothesis formulated in question (ii) and indicate a promising dual anti-biofouling effect.
Certain limitations must be addressed. This study was conducted in an in vitro setting with standardized human bile and selected microbial species. While this model approximates physiological conditions, in vivo factors, such as bile flow dynamics, immune interactions, and long-term biocompatibility, require further investigation. Future studies should include animal models or clinical pilot trials to evaluate the translational applicability of DLC-Ag-coated biliary stents.